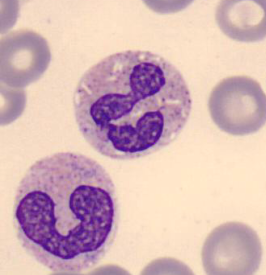

TEJIDOS
1/88
Earn XP
Description and Tags
flashcards del tejido epitelial, muscular, conectivo y nervioso
Name | Mastery | Learn | Test | Matching | Spaced | Call with Kai | Chat |
|---|
No analytics yet
Send a link to your students to track their progress
89 Terms
Ectodermo
Sistema nervioso
Piel
Mesodermo
Músculos
Esqueleto
Riñones
Aparato reproductor
Endodermo
Glándulas endocrinas
Pulmones
Hígado
Sistema Digestivo
Tejidos Epiteliales
Cubren superficie corporal
No presentan sustancia intercelular
Están sobre una MEMBRANA BASAL acelular (formada por fibras y disacáridos)
Su zona más externa es la APICAL
No vasos sanguíneos
Gran regeneración
Tipos de Epitelios
Revestimiento
Glandulares
Epitelios de Revestimiento
Simples (una capa)
Estratificados (dos o más capas)

Epitelial Simple PLANO (más anchas que altas)
Descripción: Células planas dispuestas de una sola capa
Localización: Pulmones, Revestimientos de los vasos sanguíneos (endotelio) y Glomérulos en el riñón
Función: Paso de materiales donde se requiere poca o ninguna protección. Difusión es principal forma de transporte


Epitelial Simple CUBOIDE (igual de altas y anchas)
Descripción: De lado asemejan un cilindro perfecto
Localización: Revestimientos renales, Conductos glandulares y Cuerpo ciliar del ojo
Función: Secreción y Absorción


Epitelial Simple Cilíndrico (más altas que anchas)
Descripción: Una sola capa de células altas y delgadas con núcleos alargados en la región basal de las células.
Localización: Estómago, superficie mucosa del intestino, trompas de falopio, vesícula biliar
Función: Secreción de moco, absorción, protección, movimiento de capa mucosa


E. S. Cilíndrico con Microvellosidades cortas y Células Caliciformes
Localización: tracto digestivo, intestino delgado y estómago
Función: células caliciformes glandulares son un tipo de célula cilíndrica simple que funciona para secretar mucinas


E. S. Cilíndrico con Cilios y Células Caliciformes
Localización: Tracto respiratorio, trompas de falopio, útero, conducto de médula espinal
Función: Eliminación o de movimiento de sustancias o cuerpos extraños muy pequeños (Protección)

E. S. Cilíndrico con Microvellosidades Largas
Localización: Epidídimo
Función: microvellosidades aumentan el área de superficie para la absorción


E. S. Cilíndrico Seudoestratificado
Descripción: Todas las células hacen contacto con la lámina basal, pero no todas alcanzan la superficie, por lo que parecen varias capas. Núcleos arriba y abajo. Tienen células caliciformes y cilios tmb
Localización: Vías respiratorias (tráquea)
Función: Secreción, absorción y movimiento de moco

Tejido Epitelial Estratificado Plano
Formado de varias capas difíciles de contar
Capa superficial son células planas
Puede presentar células muertas (estrato córneo) en la piel. En otros casos (esófago y lengua) no tiene.

E. Estratificado Plano (piel delgada)
Descripción: Varias capas de células que son planas hacia la zona apical y columnares hacia la superficie basal. Metabólicamente activas
Localización: Lengua, esófago, cervix
Función: Solo protección, escasa o nula absorción o tránsito de materiales


E. Estratificado Plano (piel gruesa)
Descripción: Capa córnea (queratinizada) + E. E. Plano
Localización: Manos y Pies
Función: Protección, escasa o nula absorción de materiales

Estratos de la piel Gruesa
Estrato corneo: lleno de células muertas llenas de queratina. no núcleo
Estrato lúcido: células muertas que acaban de morir. no núcleo
Estrato granuloso: lleno de queratohialina (precursora de queratina). no núcleo
Estrato espinoso: Líneas blancas son desmosomas con uniones celulares para que las células se comuniquen unas con otras
Estrato basal o germinativo: sus células sufren mitosis (son las que van regenerando las células). tmb tienen melanina (protege al colágeno)

Epitelio Estratificado Cúbico
Dos capas de células donde ambas son cúbicas
ej: algunas porciones de las glándulas sudoríparas

E. Estratificado Cúbico
Descripción: dos capas de células en donde ambas son cúbicas.
Localización: conductos excretores de glándulas grandes, como las sudoríparas, salivales y mamarias.
Función: Proporciona protección y puede participar en la secreción o absorción de sustancias

Epitelio de Transición
Tipo de E. Estratificado
Células cambian de forma al contraerse
Tienen forma cuboide pero puede cambiar a plana
Las células superficiales tienen mayor tamaño que las inferiores y poseen 2 núcleos.
No hay membrana basal
La luz es estrellada/irregular

E. de Transición
Descripción: Estratificado. Células cambian de forma al contraerse
Localización: epitelio que reviste a la vejiga urinaria, uréteres y pelvis renal.
Función: Barrera

Epitelio Glandular
Una o varias capas de c. epiteliales
sufren invaginación, donde las células epiteliales se pliegan hacia adentro
Producción y Secreción de sustancias (leche, sudor, cera, saliva, cebo, hormonas, enzimas)
Unicelulares (Cél. Caliciformes)
Multicelulares (glándulas). Según ramificación de conductos pueden ser simples o compuestas
Tipo de secreción:
SEROSA: Rica en glucoproteínas
MUCOSA: Producen mucina
MIXTO: Mucina y Glucoproteínas
Modo de secreción:
Merocrino: No hay lesión (saliva)
Apocrino: Pérdida parcial de citoplasma (glán. mamaria)
Holocrino: Destrucción de la célula (glán. sebáceas)

Modo de Secreción
Merocrina. (Gl. Salivares)


Modo de Secreción
Apocrina. (Gl. mamaria)


Modo de Secreción
Holocrina. (Gl. sebáceas)


Tipo de Secreción
Acino Mucoso (es pálido en medio)


Tipo de Secreción
Acino Seroso (es oscuro en el medio)


TIpo de secreción
Acino Mixto (tiene parte oscura y clara)

Secreción
Sustancia biológicamente activa sintetizada por las células que componen una glándula.
Células que forman secreciones son GLANDULARES
Glándulas Endocrinas
No conductos excretores
Hormonas entran directo en la sangre
Ej. Hipófisis, tiroides, paratiroides, suprarrenales, islotes pancreáticos, etc
Glándulas exocrinas
Vierten secreción en la superficie de la piel o en cavidades de los órganos
Porción secretora + Conducto excretor
Ej. Glándulas sebáceas

Células Caliciformes
E. Glandular Unicelular que secretan moco.


Glándulas Sebáceas
E. Glandular Pluricelular (exocrina).
Asociada a lugares donde hay folículos polisos
No en manos o pies


E. Glandular Pluricelular (endocrina)
Tipo FOLICULAR (tiroides)
Alrededor: Células foliculares
Adentro: Hormona Coloide

Tejido Muscular
Mesodermo (central)
Músculo Esquelético
Unido al esqueleto
Control Voluntario
Fibras alargadas y cilíndricas. Extremos circulares
Muchos NÚCLEOS x Fibra
Núcleos en PERIFERIA
Mayor rapidez de contracción
Menor duración de contracción
Músculo Liso
Paredes de vísceras
Control involuntario
Alargadas, grueso en el medio, puntas puntiagudas
1 Núcleo x Fibra
Núcleos en CENTRO
Menor rapidez de contracción
Mayor duración de contracción (hasta 3 horas)
Músculo Cardiaco
Paredes del corazón
Control involuntario
Fibras cilindricas ramificadas y fusionadas
2 Núcleos x Fibra
Núcleos en CENTRO
Intermedia rapidez y duración de contracción

Músculo Esquelítico.
Estriado (z lines)
Oscuras son A Bands
Claras son I Bands
NÚCLEOS EN PERIFÉRIA !!


Músculo Cardiaco
Fibra ramificada
DISCOS INTERCALARES
Estrías transversales e intercaladas
NÚCLEO CENTRAL


Músculo Liso
Alargados
NÚCLEO CENTRAL

Tejido Conectivo
El tejido conectivo está formado por la matriz extracelular que contiene FIBRAS y las CÉLULAS CONECTIVAS de distintos tipos.
Origen Embriológico: Mesodermico
Funciones del Tejido Conectivo
Sostiene ÓRGANOS y CÉLULAS
Medio de Intercambio de nutrimentos y desechos entre SANGRE y TEJIDOS
Protege de microorganismos
Repara tejidos dañados
Almacena grasa
Tipos de Fibras Conectivas
Colágeno
Grandes y Gruesas
Proporcionan resistencia y soporte
Más abundantes (piel, ligamentos, tendones)
Reticulares
Tipo de fibras de colágeno. Necesitan tinte especial
Finas y Ramificadas
Retículo forma malla de soporte celular en órganos (riñón, ganglios, bazo e hígado)
Elásticas
Ramificadas y más delgadas que las colágenas
Tienen formas de ondas
Asociadas a organos que se retraen (vasos sanguíneos)
División de los Tejidos Conectivos
Laxos
Embrionarios
Mucoso
Mesenquimatoso
Adultos
Adiposo
Densos
Regular
Irregular
Especializados
Cartílago
Hialino
Elástico
Fibrocartílago
Óseo
Sangre
Hematopoyético


TC Embrionario MUCOSO
(cordón umbilical→gelatina de warthon)
Fibras de Colágeno
Tinción especial para que se vean las fibras de colágeno
Fibroblastos
Células activas pero inmaduras
Función de producir fibras de colágeno


TC Embrionario MESENQUIMÉTICO
Fibras reticulares fiiiinas
Se encuentra en fetos
Células mesenquimatosas son células madres PLURIPOTENCIALES


TC Adulto Adiposo
Tinción Hematoxilina eosina
En el medio están las células de grasa (adiposito)
Los núcleos son empujados hacia afuera
Almacenan energía y amortiguan golpes


TC Denso Irregular
Denso bc MUCHAS fibras de colágeno
Irregular bc fibras de colágeno están en desorden.
Ubicados en dermis de la piel


TC Denso Regular
Denso bc MUCHAS fibras de colágeno
Regular bc son Grandes de manera ordenada
Van en misma dirección que fibroblastos
Ubicados en ligamentos y tendones
Función de resistencia y tensión


TC Especializado Cartílago Hialino
Pericondrio RODEA al cartílago
Son como espacios blancos y dentro hay bolitas. El cartílago es medio gris
Se encuentra en la TRÁQUEA


Partes del Tejido Especializado Cartilaginoso
Pericondrio
Rodea el cartílago
Condroblastos
Células maduras que van hacia el interior y se les deposita una cavidad llamada lagunas de condroblastos
Condrocitos
células especializadas responsables de la síntesis y mantenimiento de la matriz extracelular
Lagunas o Condroplastos
Son espacios en la matriz cartilaginosa que contienen a los condrocitos.


TC Especializado Cartílago Elástico
Se ven los condrocitos, las lagunas y las fibras elásticas
En la EPIGLOTIS


TC Especializado Cartílago Fibroso (Fibrocartílago)
No tiene pericordio
Ubicado en discos intervertevrales
Se encuentra en lugares de mucha tensión y carga en el cuerpo.


TC Especializado Óseo
Osteocitos
Célula ósea madura
Osteoplasto
Lagunilla del osteocito
Osteoblasto
Sufren mitosis y reemplazan los osteócitos cuando maduren


TC Especializado Óseo (Hueso Pulido y Seco)
Osteonas
Conjunto de Canales de Havers, lagunillas y laminillas concéntricas

Tejido Conectivo Especial SANGRE
Componentes
Elementos Formes
Eritrocitos
Leucocitos granulares y agranulares
Plaquetas
Plasma
Funciones
Transporte
Regulación
Protección
Glóbulos Rojos o Eritrocitos
Carecen de núcleo
No sufren división celular
Son bicóncavos y FLEXIBLES
En su membrana encontramos lípidos, proteínas y carbohidratos
ABO determinado por un oligosacárido sobre glicoproteínas y glicolípidos de la membrana
Vida promedio de 120 días
Los dañados son eliminados en el HÍGADO y BAZO
Función
Transporta O₂, CO₂ y Hb
Rangos normales de Glóbulos Rojos
Hombre
de 4.7 a 6.1 millones de células/µL en sangre.
Mujer
de 4.2 a 5.4 millones de células/µL en sangre.
*/µL → microlitro
Glóbulos Blancos o Leucocitos
Se originan en células madres en la MÉDULA ÓSEA ROJA y se desarrollan antes de entrar a sangre
Contienen núcleo y organelos
Son Granulocitos o Agranulocitos
No se conoce vida promedio
Desgastados son destruídos en HÍGADO y BAZO
Rangos Normales de Leucocitos
Adulto
# promedio de 5k a 9k/µL
Es mayor al nacimiento y disminuye entre los 10-12 años
Leucocitosis
Muchos leucocitos
Leucopenia
Pocos leucocitos
Granulocitos
Reciben su nombre de acuerdo al color que se tiñen los gránulos del citoplasma
Eosinófilos
Eosina (naranja rojizo)
Basófilos
azul de metileno alcalino
Neutrófilos
morados (rojos y azules)
Agranulocitos
Monocitos
citoplasma azul-gris
Linfocito
citoplasma azul
Forma borde alrededor del núcleo que se tiñe oscuro
TC Especial Sangre (Neutrófilos)
Citoplasma MORADO
Núcleo con 2 a 5 lóbulos
Granulaciones finas
Junto a Linfocitos los más numerosos
Protege contra microorganismos
AUMENTA EN:
Infecciones microbianas, leucemia, quemaduras, estrés e inflamación, etapas finales del embarazo, tabaquismo intenso, anticonceptivos orales


TC Especial Sangre (Eosinófilos)
Citoplasma ROJO
Núcleo con 2 lóbulos
Gránulos gruesos y toscos
Abundantes en recubrimeintos del aparato digestivo y respiratorio
AUMENTA EN
Alergias (asma), fiebre, sensibilidad a alimentos y fármacos.
Protegen contra infecciones por gusanos


TC Especial Sangre (Basófilos)
Citoplasma ROJO PÚRPURA OSCURO
Sus núcleos son borrosos/no se ven
Gránulos MUY GRANDES
Son móviles y capaces de diapédesis (pasar a través de las paredes de los vasos)
AUMENTA EN
rx alergias, leucemias (cánceres), hipertiroidismo


TC Especial Sangre (Monocitos)
Citoplasma azul-gris
Leucocitos más GRANDES
Núcleos oscuros con forma de C o Frijol
No gránulos
Móvilos y muy fagocíticos
Absorben bacterias y células infectadas por virus
AUMENTAN EN
infecciones virales, micosis (infecciones x hongos), tuberculosis, algunas leucemias


TC Especial Sangre (Linfocitos)
Poco citoplasma, núcleo grande
Leucocitos más pequeños
Junto a Neutrófilos los más numerosos
Dos tipos
T (ataca células)
B (produce anticuerpos)
AUMENTAN EN
Infecciones virales y algunas leucemias

Números normales de Leucocitos
Neutrófilos → 60% - 70%
Linfocitos → 20% - 25%
Monocitos → 3% - 8%
Eosinófilos→ 2% - 5%
Basófilos → 0.5% - 1%
Plaquetas
Cuerpos pequeños casi incoloros. Ovalados
Función en la hemostasia y coagulación sanguínea
Se forman en la médula ósea roja
Originan de los megacarioblastos
Vida media de 9 días
Volumen normal de plaquetas
150k - 400k plaquetas/µL
Trombocitosis
Muchas plaquetas
Trombocitopenia
Pocas plaquetas

TC Especial Sangre (Plaquetas)

Tejido Nervioso
Conforma Sistema Nervioso (duh)
Se encarga de TRANSMISIÓN de flujo de INFORMACIÓN
Responde a ESTÍMULOS externos e internos
Función principal es la capacidad de respuesta ante condiciones cambiantes que ayudan a la SUPERVIVENCIA del individuo

Partes de una neurona
Dendritas
Sustancia de Nissl
Encargada de la síntesis de proteínas dentro de las neuronas
Cuerpo o Soma
Núcleo
Cono axónico
Nodos de Ranvier
Depresiones en la vaina de mielina (donde hay menos mielina)
Vaina de mielina
Recubre al axón y lo aisla electricamente.
Aumenta la velocidad de conducción de Impulsos Nerviosos
Formada por lípidos y proteínas (en el microscopio se ve blanco pq el tinte es a base de agua).
No se regeneran
Axón
Botones sinápticos o Vesículas sinápticas: La manera en que las neuronas se comunican unas con otras

Neuronas
Unidad estructural y funcional del tejido nervioso
Muy especializada
Excitable y conductora
Partes de neurona (Cuerpo)
En el citoplasma:
Núcleo
Sustancia cromatófila/de Nissl (síntesis de proteínas)
Neurofibrillas (sostén y forma a la neurona)
Lipofuscina (producto de los lisosomas)
Partes de la neurona (prolongaciones)
Dendritas
Conducen impulsos hacia cuerpo celular. (aferentes)
Axón
Axoplasma, axolema, ramificaciones laterales. NEUROTRANSMISORES
Conducen impulsos desde el cuerpo neuronal (eferentes)

Sinapsis: conexiones entre neuronas.
Célula presináptica: Tiene vesículas con neurotransmisores
Neurotransmisores: sustancias que transmiten señales entre neuronas.
Células postsinápticas: Tiene los receptores de neurotransmisores


Clasificación Estructural de las Neuronas
Monopolar
Una sola prolongación de doble sentido (actúa como dendrita y como azón / entrada y salida)
Bipolar
Dos prolongaciones. Una es dendrita y otra es axón
Multipolar
Más típicas y abundantes.
Gran número de dendritas (entrada) y un solo axón (salida)
Clasificación funcional de las Neuronas
Neuronas AFERENTES o sensitivas (cuerpo a cerebro)
Neuronas EFERENTES o motoras (cerebro a cuerpo)
Neuronas de ASOCIACIÓN o interneuronas (mediador entre ambas)
Ej. Neuronas de Purkinje
Neuroglias (o células de la glía)
Características:
No son excitables.
Pueden multiplicarse y dividirse. Ocupan la mitad del volumen del SN
Cuando se hacen tumores, se llaman GLIOMAS
Función
Sostener, Proteger, Aislar y Nutrir a las neuronas

Clasificación de las Neuroglias
Astrocitos
Metabolizan los neurotransmisores
Mantienen el eq de K para generar impulsos nerviosos
Participan en la barrera HEMATOENCEFÁLICA (Barrera para impedir que los microorganismos aciendan al SN central)
Oligodendrocitos
Producen la vaina de mielina (1 puede mielinizar VARIOS axones)
Sostienen las neuronas del SNC
Son más pequeños que los astrocitos
Microglia
Pueden fagocitar (Se come a las neuronas muertas)
Células Ependimarias
Están al rededor del canal central y de los ventrículos cerebrales

Neuroglias en el SNP
Células de Schwan
Producen vaina de mielina (a 1 solo axón)
Células de Satélite
Sostienen a las neuronas de los ganglios
Envolturas Protectoras del Cerebro
Meninges
Duramadre (pegada al cráneo)
Espacio subdural
Aracnoides
Espacio subaracnoideo
Piamadre (pegada al cerebro)
Vasos sanguíneos
Barrera Hematoencefálica
Solo la atraviesan O2, OH, CO2 y muchos anestésicos

Sustancias en el Cerebro
Sustancia Blanca (hacia adentro)
Sustancia Gris (varias capas, hacia afuera)

Neurona Triangular
Oligodendrocitos


Corteza del Cerebelo (capas de sustancia gris)
Capa molecular
POQUIIIITAS células
Capa de Células de Purkinje
Neuronas de transición, son grandes
Capa granular
LLENA de células de la granulosa (circulares)

Médula Espinal
Somas neuronales en los astas anteriores son GRANDES
Piamadre rodea a la médula espinal (material fibroso pálido)

Identificación en Médula Espinal
Astas
Anterior
Gruesas y Cortas (hay neuronas eferentes/motoras)
Posteriores
Largas y Delgadas
Sustancias
Gris
Parte interior donde hay neuronas
Blanca
Parte exterior
Canal Central
